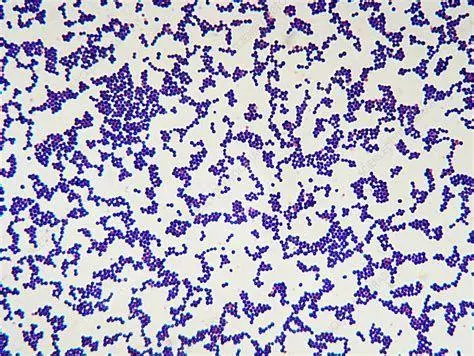
Bakteri Staphylococcus Bakteri Staphylococcus aureus penyebab infeksi mata

Penyebab Mata Bintitan yang Perlu Diwaspadai Demi Kesehatan Indera Penglihatan
Banyak orang masih percaya bahwa penyebab mata bintitan adalah karena kebiasaan mengintip. Faktanya, dalam dunia medis, bintitan atau yang secara klinis disebut sebagai hordeolum, sama sekali tidak ada hubungannya dengan aktivitas tersebut. Bintitan merupakan kondisi peradangan atau infeksi pada kelenjar di tepi kelopak mata yang menimbulkan benjolan kecil menyerupai jerawat. Benjolan ini biasanya disertai dengan rasa nyeri, kemerahan, dan pembengkakan yang mengganggu kenyamanan penglihatan maupun penampilan.
Memahami akar permasalahan dari munculnya benjolan ini sangatlah penting agar kita tidak terjebak dalam mitos yang menyesatkan. Secara umum, hordeolum muncul akibat adanya sumbatan pada saluran kelenjar minyak yang kemudian terinfeksi oleh patogen. Meskipun seringkali dianggap sebagai masalah ringan yang bisa sembuh dengan sendirinya, bintitan yang tidak ditangani dengan benar dapat memicu komplikasi seperti selulitis preseptal atau penyebaran infeksi ke area kelopak mata yang lebih luas.
Mengenal Mekanisme Terjadinya Hordeolum
Hordeolum terjadi ketika kelenjar di sekitar kelopak mata tersumbat oleh sel kulit mati, kotoran, atau sisa riasan wajah. Kelopak mata manusia memiliki banyak kelenjar kecil, di antaranya adalah kelenjar Meibom, kelenjar Zeis, dan kelenjar Moll. Ketika saluran ini buntu, minyak (sebum) yang seharusnya keluar untuk melumasi bola mata justru terjebak di dalam. Lingkungan yang lembap dan kaya lemak ini menjadi tempat yang sangat ideal bagi bakteri untuk berkembang biak dengan cepat.
Berdasarkan lokasinya, bintitan terbagi menjadi dua jenis utama, yaitu hordeolum eksternum yang muncul di pangkal bulu mata dan hordeolum internum yang terjadi di bagian dalam kelopak mata. Keduanya memiliki pemicu yang serupa namun memerlukan tingkat kewaspadaan yang berbeda, terutama jika benjolan tersebut tidak kunjung mengecil dalam hitungan hari atau justru semakin mengeras.
Berbagai Penyebab Mata Bintitan yang Paling Umum
Faktor utama yang menjadi dalang di balik munculnya benjolan ini adalah infeksi bakteri Staphylococcus. Bakteri ini sebenarnya secara alami hidup di kulit manusia tanpa menimbulkan masalah, namun jika berpindah ke area mata melalui tangan yang kotor atau alat kosmetik yang terkontaminasi, ia dapat memicu peradangan hebat. Berikut adalah rincian penyebab yang harus Anda ketahui:
1. Infeksi Bakteri Staphylococcus Aureus
Hampir 90% kasus bintitan disebabkan oleh serangan bakteri Staphylococcus aureus. Bakteri ini masuk ke dalam folikel bulu mata atau kelenjar minyak saat sistem pertahanan lokal di area mata sedang melemah. Perpindahan bakteri paling sering terjadi melalui sentuhan tangan secara langsung. Jika Anda sering mengucek mata tanpa mencuci tangan terlebih dahulu, risiko bakteri ini masuk ke pori-pori kelopak mata akan meningkat secara signifikan.
2. Peradangan Kelopak Mata Kronis (Blefaritis)
Orang yang menderita blefaritis memiliki risiko jauh lebih tinggi untuk mengalami bintitan berulang. Blefaritis adalah kondisi di mana tepi kelopak mata menjadi merah, bengkak, dan berminyak. Peradangan kronis ini seringkali menyumbat pori-pori tempat tumbuhnya bulu mata, sehingga sebum menumpuk dan memicu terbentuknya hordeolum. Jika Anda sering mengalami bintitan, ada kemungkinan Anda memiliki masalah blefaritis yang mendasarinya.
3. Disfungsi Kelenjar Meibom
Kelenjar Meibom berfungsi memproduksi komponen minyak dari air mata kita. Jika kelenjar ini tidak berfungsi dengan baik atau tersumbat secara kronis, minyak yang dihasilkan menjadi terlalu kental. Minyak yang kental ini tidak dapat mengalir dengan lancar, menciptakan sumbatan yang menjadi pintu masuk bagi infeksi bakteri. Kondisi ini sering dikaitkan dengan penyakit kulit seperti rosacea atau dermatitis seboroik.
Faktor Risiko dan Gaya Hidup yang Berpengaruh
Selain penyebab langsung berupa kuman, terdapat beberapa faktor risiko yang memperbesar peluang seseorang terkena bintitan. Gaya hidup yang kurang higienis menempati urutan teratas sebagai pemicu masalah ini. Berikut adalah tabel perbandingan faktor risiko yang sering ditemukan di masyarakat:
| Faktor Risiko | Dampak pada Kelopak Mata | Tingkat Risiko |
|---|---|---|
| Kebiasaan mengucek mata | Memindahkan kuman dari tangan ke mata | Tinggi |
| Penggunaan lensa kontak tidak steril | Infeksi bakteri langsung ke permukaan mata | Sangat Tinggi |
| Kosmetik kedaluwarsa | Pertumbuhan jamur dan bakteri pada aplikator | Sedang |
| Kurang tidur & stres | Menurunkan sistem imun tubuh secara umum | Sedang |
| Diabetes melitus | Memperlambat proses penyembuhan infeksi | Tinggi |
Penting bagi pengguna kosmetik untuk selalu mengecek masa berlaku produk seperti maskara atau eyeliner. Produk yang sudah terbuka lebih dari tiga bulan biasanya sudah menjadi sarang bakteri. Selain itu, tidak membersihkan riasan sebelum tidur adalah kesalahan fatal yang membuat kelenjar minyak tersumbat sepanjang malam.
"Kebersihan tangan adalah kunci utama dalam mencegah perpindahan bakteri ke area wajah. Sebagian besar kasus hordeolum dapat dihindari dengan disiplin menjaga higienitas area periokular."

Langkah Penanganan Mandiri di Rumah
Jika Anda sudah mulai merasakan gejala bintitan, langkah pertama yang paling efektif adalah melakukan kompres hangat. Suhu hangat membantu mengencerkan minyak yang tersumbat di dalam kelenjar dan mempercepat drainase alami secara aman. Gunakan kain bersih yang direndam air hangat (bukan air mendidih), lalu tempelkan pada kelopak mata selama 10-15 menit, lakukan 4 kali sehari.
Satu hal yang DILARANG KERAS adalah memencet atau mencoba memecahkan benjolan bintitan layaknya jerawat. Tindakan ini justru akan mendorong bakteri masuk lebih dalam ke jaringan lunak di sekitar mata dan bisa menyebabkan infeksi yang jauh lebih serius. Biarkan benjolan tersebut pecah secara alami atau mengecil dengan sendirinya setelah dikompres secara rutin.
Kapan Harus Menghubungi Dokter Spesialis Mata?
Walaupun bintitan biasanya bisa sembuh dalam waktu 1-2 minggu dengan perawatan rumah, ada kondisi tertentu yang memerlukan intervensi medis profesional. Segera konsultasikan ke dokter mata jika Anda mengalami gejala sebagai berikut:
- Pembengkakan menyebar hingga ke pipi atau seluruh area sekitar mata.
- Penglihatan menjadi buram atau terganggu.
- Rasa nyeri yang sangat hebat dan tidak kunjung reda.
- Bintitan tidak kunjung pecah atau mengecil setelah lebih dari 10 hari.
- Muncul darah atau nanah yang sangat banyak dari benjolan.
Dokter mungkin akan meresepkan salep antibiotik atau obat tetes mata untuk membunuh bakteri. Dalam beberapa kasus hordeolum yang membandel (kalazion), prosedur bedah kecil berupa insisi dan kuretase mungkin diperlukan untuk mengeluarkan isi benjolan di bawah pengawasan medis yang steril.

Upaya Pencegahan Jangka Panjang
Mencegah jauh lebih baik daripada mengobati. Langkah pencegahan yang paling mendasar adalah dengan membangun rutinitas kebersihan wajah yang konsisten. Bagi pemilik kulit berminyak atau penderita blefaritis, mencuci tepi kelopak mata secara lembut menggunakan sampo bayi yang tidak perih di mata dapat membantu menjaga saluran kelenjar tetap terbuka. Pastikan juga untuk selalu mencuci tangan dengan sabun sebelum dan sesudah menyentuh area wajah.
Secara keseluruhan, pemahaman yang benar mengenai penyebab mata bintitan membantu kita untuk mengambil tindakan pencegahan yang lebih rasional daripada sekadar memercayai mitos lama. Dengan menjaga kebersihan lingkungan, alat rias, dan kesehatan tubuh secara general, risiko terkena infeksi mata yang mengganggu ini dapat diminimalisir secara efektif. Kesehatan mata adalah aset berharga, maka jagalah dari hal-hal kecil yang sering kita abaikan dalam keseharian.


What's Your Reaction?
-
0
 Like
Like -
0
 Dislike
Dislike -
0
 Funny
Funny -
0
 Angry
Angry -
0
 Sad
Sad -
0
 Wow
Wow






